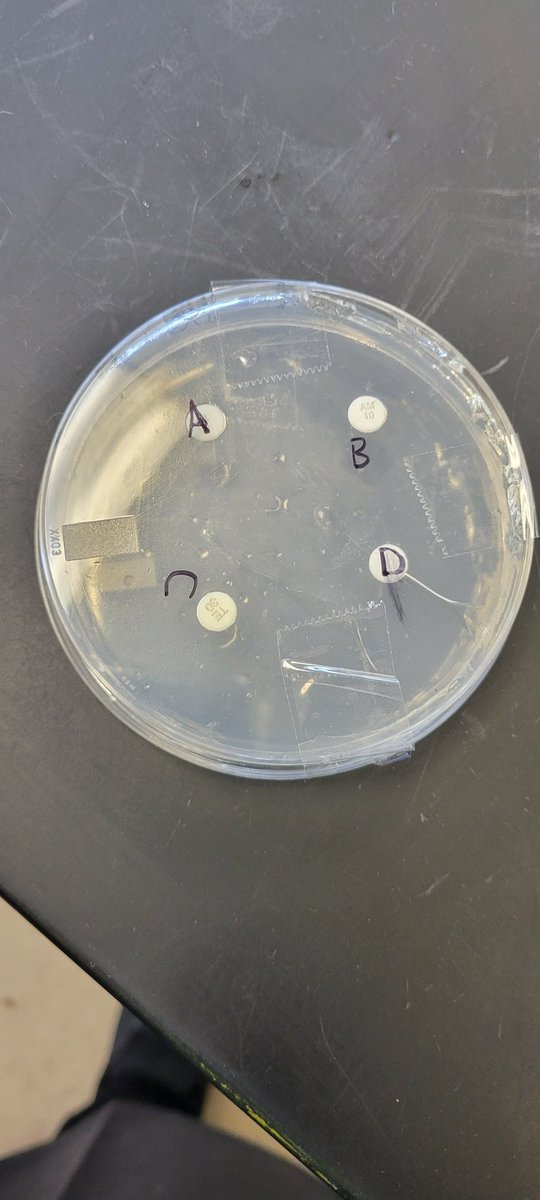
Antibiotic lab. Students were very dillagent about safety! They are awesome! <a href="/OpalHFord/">Opal Harrison Ford</a> <a href="/AEMA_JDMS/">Academy of Energy, Medicine and Aerospace at JDMS</a>

Kendra.Low
@kendralow2
Retired Science Educator!
ID: 1255489380745195525
29-04-2020 13:29:42
106 Tweet
44 Followers
112 Following




These turned out so good! Pepperoni bread for the win! HomeCookSingleMom HappilyTakenNurse Deb


The process of learning about your body systems can be fun! How DO the systems work together?? Academy of Energy, Medicine and Aerospace at JDMS


The digestive system is so strange! According to the students it is eww but so cool! Academy of Energy, Medicine and Aerospace at JDMS



Ready for the students to work on their antibiotic lab. Going to be an interesting experience! Opal Harrison Ford Academy of Energy, Medicine and Aerospace at JDMS


Antibiotic lab. Students were very dillagent about safety! They are awesome! Opal Harrison Ford Academy of Energy, Medicine and Aerospace at JDMS

While learning about stimuli and response, it was obvious that the eye plays an important role. So let us see what is the structure and function of the eye! Academy of Energy, Medicine and Aerospace at JDMS Opal Harrison Ford


Creativity abounds in Medical Detectives class! Making a model of a neuron using craft supplies. The possibilities are endless! Academy of Energy, Medicine and Aerospace at JDMS Opal Harrison Ford


When faced with the challenge 'what happens when structure does NOT meet function?' These students rise to the occasion! Academy of Energy, Medicine and Aerospace at JDMS Opal Harrison Ford
















